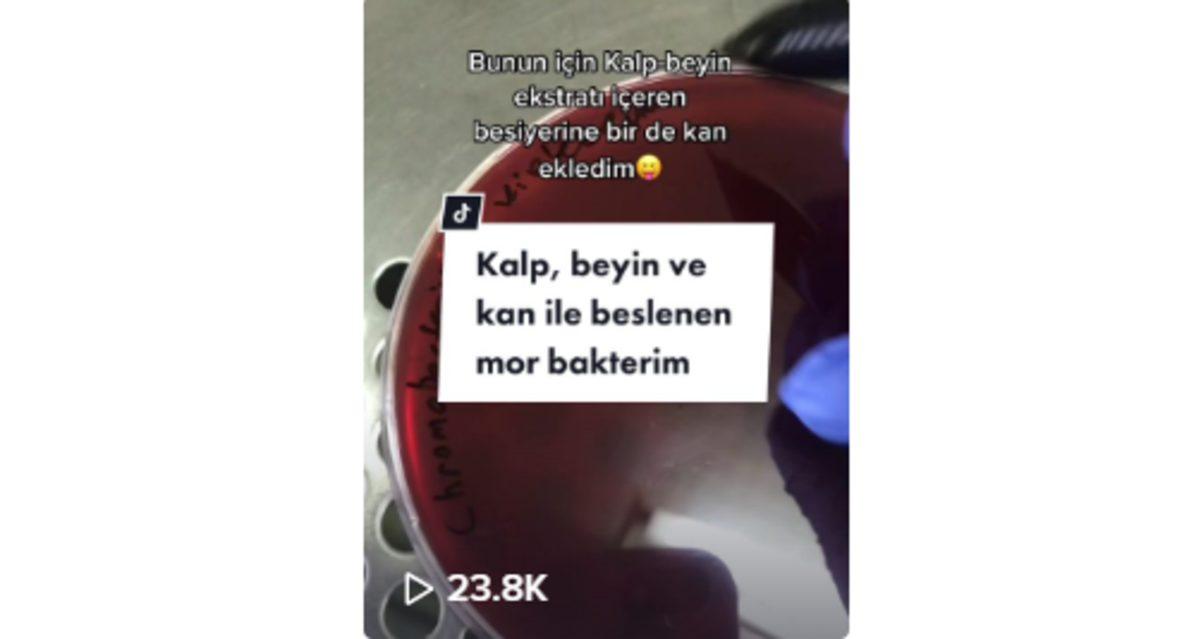
Samanlıkta İğne Aradık: TikTok’ta Takip Edebileceğiniz 9 Faydalı Hesap

TikTok, genel olarak arkada müzikler eşliğinde ve filtrelerle hazırlanan kısa videoların yayınlandığı bir sosyal medya platformu. Ayrıca canlı yayın açabilme gibi özelliklere sahip olduğu için telefonda vakit geçirmek isteyenlerin sıklıkla başvurduğu bir uyguluma.
Sosyal medyayı az çok kullanan herkesin artık bir şekilde bildiği, videolarını bir yerlerden denk gelip izlediği bir platform olarak TikTok; her gün yeni bir akım ortaya çıkartabiliyor. Videolarda kullanılan müzikler dahi trend haline gelebiliyor. İçinde büyük bir karmaşa barındıran TikTok'u sizin için taradık ve faydalı olabilecek içerik üreticilerini derledik.
TikTok'ta Takip Edebileceğiniz 9 Faydalı Hesap
- Salavat Fidai
- Aleyna Kılıç
- Pinky Pearly
- Evrim Ağacı
- 1 Dakikada İngilizce
- Jordi Koalitic
- Ben Treat
- Nursema
- Rizvanov
Minyatür heykellerle şaheserler yaratan bir sanatçı: Salavat Fidai

- Kullanıcı adı: @salavat.fidai
- Takipçi sayısı: 12.8 milyon
- Beğeni sayısı: 258.2 milyon
Salavat Fidai, Rus asıllı bir heykeltıraş. Onu, diğer meslektaşlarından ayıran özelliği ise sanat eserlerini, işlemesi zor olan nesneler üzerine yapması. Fidai, 25 yılı aşkın avukat olarak sürdürdüğü kariyerine, Rusya'da başlayan ekonomik kriz sonrasında tam zamanlı sanatçı olarak devam etme kararı aldı.
Bir süre dijital fotoğrafçılık yolunda natürmort eserlere odaklandı. Daha sonrasında ise minyatür sanata ilgisi arttı ve kabak çekirdeği, pirinç taneleri gibi işlemesi oldukça zor olan şeyler üzerine minyatür resimler yapmaya başladı. Fakat tüm bu sürecin sonunda TikTok gibi bir mecrada dahi tanınır hale gelmesini sağlayan yeni bir yol buldu: Kurşun kalem uçları.
Fidai, oldukça kırılgan bir yapıda olan kurşun kalem uçlarına, bazen saatler bazen günler süren emekleri sonucu oldukça mikro heykeller çıkarmayı başarıyor. Mikro heykelleri dünya çapında sanat müzelerinde sergilenen sanatçının tanınır hale gelmesinde sosyal medyadaki aktifliği de fayda sağlıyor.
İşaret dili öğrenmek isteyenler için: Aleyna Kılıç

- Kullanıcı adı: @aleykilic
- Takipçi sayısı: 82 bin
- Beğeni sayısı: 1.6 milyon
Yeni videoları biraz daha dans veya sohbet içerikli eğlence üzerine olsa da TikTok'a ilk girdiği videolar, işaret dili kullanımıyla ilgiliydi. Gündelik hayatımızda sürekli kullandığımız belli başlı kelimeleri, cümle kalıplarını işaret dilinde nasıl göstereceğimizi anlatan videolar çeken Aleyna Kılıç, bazen kendi hayatından veya sevdiği şarkı sözlerinden de işaret dili kullanımını öğreten videolar çekiyor.
Bakterileri daha yakından tanımak isteyenler için: Pinky Pearly
- Kullanıcı adı: @pinkypearly
- Takipçi sayısı: 58.4 bin
- Beğeni sayısı: 885.8 milyon
Mikrobiyolog bir araştırmacı olan ve TikTok'ta renkli saçlarıyla uyumlu Pinky Pearly adıyla videolar çeken Deniz Periz; çalıştığı laboratuvarda yaptığı deneylerle yüksek bir beğeni sayısına ulaşmayı başardı. Buzdolabından marula, saç derisinden bulaşık süngerine çevremizde gördüğümüz birçok şeyin bakteri seviyesini ölçen Pinky Pearly, aynı zamanda antibakteriyel olduğu düşünülen ürünleri de inceliyor. Mikrobiyoloji hakkında bilgisi olmayan insanların bile eğlenceli anlatımı sayesinde ilgisini çekebilen Pinky Pearly, TikTok'ta takip edilmeye değer hesaplardan biri.
"Neden?" sorularına aradığımız cevaplar: Evrim Ağacı

- Kullanıcı adı: @evrimagaci
- Takipçi sayısı: 360.5 bin
- Beğeni sayısı: 4.6 milyon
'Karanlığı bilimle fethet!' sloganıyla 2010'da ODTÜ Biyoloji ve Genetik Kulübü üyeleri tarafından kurulmuş olan Evrim Ağacı, oldukça popüler bir bilim platformu. Bilimsel makalelere dayanarak aktif olarak paylaşım yaptıkları sitelerinin haricinde TikTok da dahil çoğu sosyal medya platformunu kullanıyorlar. TikTok hesaplarında ise mide guruldamasının neden oluştuğundan Güneş'i suyla söndürülebilme olanağına kadar, belki de gündelik hayatta aklımıza gelen ama cevabını bilmediğimiz sorulara, kısa ve ilgi çekici videolar eşliğinde cevap arıyorlar.
İngilizcenizi geliştirmenize yardımcı olabilecek bir hesap: 1 Dakikada İngilizce

- Kullanıcı adı: @1dakikadaingilizce
- Takipçi sayısı: 16.3 bin
- Beğeni sayısı: 170 bin
Günlük hayatta kullanılan deyimleri, cümle kalıplarını ve kelimeleri kısa videolar eşliğinde öğrenmenize olanak sağlayan hesap, İngilizcesini geliştirmek isteyenler için takip edilmesi gerekenler arasında.
Kreatif çekim teknikleri öğrenmek isteyenler için: Jordi Koalitic

- Kullanıcı adı: @jordi.koalitic
- Takipçi sayısı: 19.6 milyon
- Beğeni sayısı: 369.1 milyon
Yaratıcı fotoğrafçı ve kameraman olan İspanyol asıllı Jordi Koalitic, yaptığı şahane çekimleri kolaylıkla viral olan bir sanatçı. Başarılı işleri sayesinde Mercedes Benz, Nikon, Pepsi gibi dünya çapında markalarla çalışan Jordi Koalitic, TikTok'ta geniş bir kitle edinmeyi başardı. Kreatif çekim tekniklerini kısa videolar halinde takipçilerine sunarak kitlesini büyütmeye devam ediyor.
Stop-motion animasyon yapım sürecine dair: Ben Treat

- Kullanıcı adı: @franticframes
- Takipçi sayısı: 1.5 milyon
- Beğeni sayısı: 38.6 milyon
Genç yaşına rağmen stop-motion animasyon işinde oldukça başarılı işler çıkaran Ben Treat; Amazon, Netflix, Warner Music gibi dünya çapında büyük şirketlerle ortak projeler yapan bir animatör. Ben Treat, okumak yerine yaratıcı bir işte kariyer yapmayı tercih eden bir sanatçı. TikTok'ta, animasyon sürecine dair oldukça eğlenceli videoalar paylaşan Ben Treat, büyük bir kitlenin ilgisini çekmeyi başarıyor.
Hayal gücünüzü ve yaratıcılığınızı arttıran bir hesap: Nursema

- Kullanıcı adı: @nnursema
- Takipçi sayısı: 19.2 milyon
- Beğeni sayısı: 411.7 milyon
Nursema, çizim, boyama gibi şeylere ilgisi olmayanların bile dikkatini çekecek kadar keyifli videolar çeken bir hesap. TikTok akımlarına dahil olmamasına rağmen yüksek beğeni ve takipçi sayısına ulaşarak bir fenomen haline geldi. TikTok kadar YouTube'da da geniş bir kitleye sahip olan Nursema, her iki platformu da aktif olarak kullanıyor. Hayal gücünüzün ve yaratıcılığınızın artmasını istiyorsanız TikTok'ta takip edilebilecek nadir hesaplardan biri.
Photoshop kullanma taktikleri: Rizvanov

- Kullanıcı adı: @rizvanov
- Takipçi sayısı: 468.5 bin
- Beğeni sayısı: 5.6 milyon
TikTok'ta geniş bir kitlesi olan hesap, photoshop programlarıyla yapılabilecek çoğu şeyi kısa ve ilgi çekici videolar eşliğinde paylaşıyor.
Bonus - Teknolojinin en eğlenceli ve samimi hali: Webtekno

- Kullanıcı adı: @webtekno
- Takipçi sayısı: 36.4 bin
- Beğeni sayısı: 245.5 bin
Webtekno olarak; TikTok hesabımızda, merak edilen telefonların kutu açılışından challenge oyunlarına, arkadaşlara göndermelik repliklerden Netflix gizli kodlarına kadar geniş bir yelpazede içerikler paylaşıyoruz. Teknoloji alanında tuhaf sorulara cevap olabilecek videolar da paylaşarak, TikTok mecrasına renk katmaya devam ediyoruz.
